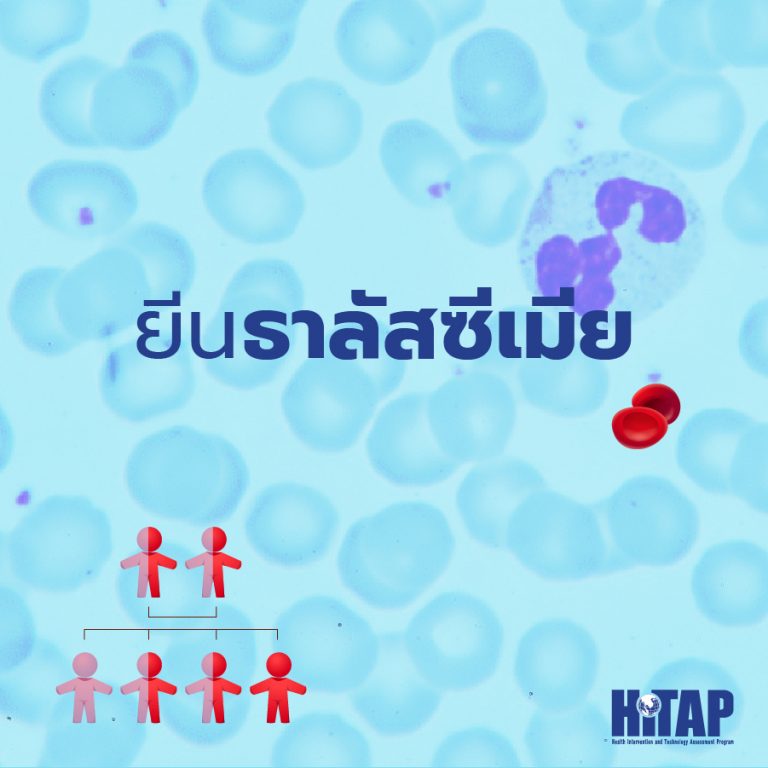

การมีสุขภาพดี สำหรับหลาย ๆ คน อาจถือได้ว่าเป็นลาภอันประเสริฐ แต่คำว่าสุขภาพดีที่ว่าอาจหมายถึงการไม่เจ็บป่วย แม้ว่าจะมีความผิดปกติอยู่ในร่างกายก็ตาม ในวันนี้ เราอยากนำเสนอ 3 สิ่งที่แม้มีอยู่ในร่างกาย ไม่ได้แปลว่าคุณจะเจ็บป่วย แต่ก็ต้องใช้ชีวิตอย่างระมัดระวังมากขึ้น เพื่อให้ชีวิตของคุณเป็นปกติที่สุดเท่าที่จะเป็นได้
1. เชื้อ HIV เป็นเชื้อไวรัสที่ทุกคนอาจจะคุ้นหูกัน เพราะเป็นต้นเหตุของโรคเอดส์ (AIDS) หลายคนอาจคิดว่าคนที่ติดเชื้อ HIV ต้องเป็นคนที่ผ่านการมีเพศสัมพันธ์มามากครั้งมากคน ซึ่งนั่นไม่ใช่ความจริงเสียทีเดียว เพราะ HIV สามารถติดต่อกันผ่านทางบาดแผล ส่งต่อจากแม่สู่ลูก หรือกระทั่งติดมาจากคู่ของตนก็ได้ ขณะนี้ เชื้อ HIV เป็นเชื้อที่ยังไม่สามารถรักษาให้หายขาดได้ แต่ถ้าหากตรวจพบเร็ว ก็สามารถใช้ยาควบคุมปริมาณเชื้อได้ และผู้ติดเชื้อจะสามารถใช้ชีวิตได้โดยไม่เจ็บป่วยใด ๆ อาการขั้นแรกของผู้ที่ติดเชื้อ HIV จะมีอาการคล้ายเป็นไข้หวัดใหญ่ ไม่ว่าจะมีไข้ เจ็บคอ ปวดเมื่อยตามร่างกาย ปวดศีรษะ มีผื่น หรือต่อมน้ำเหลืองโต หากคุณคิดว่าคุณมีอาการดังกล่าวหลังจากผ่านพฤติกรรมเสี่ยงมา พวกเราขอแนะนำให้คุณลองเข้ารับการตรวจในสถานบริการดูนะครับ ซึ่งสามารถรับการตรวจได้ฟรีที่โรงพยาบาลที่คุณมีสิทธิตามหลักประกันสุขภาพของภาครัฐ
หากคุณสงสัยว่ารัฐต้องใช้งบเท่าไหร่เพื่อให้เราได้ใช้บริการนี้ได้ฟรี สามารถศึกษาเพิ่มเติมได้ที่นี่ครับ https://www.hitap.net/research/176173
2. ยีนธาลัสซีเมีย ก่อนอื่นต้องเล่าก่อนว่าโรคธาลัสซีเมียเป็นโรคโลหิตจางที่มีเม็ดเลือดแดงผิดปกติและแตกง่าย มีโอกาสทำให้เกิดภาวะเลือดจางเรื้อรัง และสภาวะแทรกซ้อนอื่น ๆ เช่น นิ่วในถุงน้ำดี การทำงานของหัวใจและตับผิดปกติ ซึ่งโรคธาลัสซีเมียมีหลายชนิด ผู้ป่วยบางรายอาจไม่มีอาการใด ๆ เลยก็เป็นได้ แม้ว่าโรคนี้จะเป็นโรคที่รักษาได้ด้วยการปลูกถ่ายไขกระดูก แต่ยีนที่ทำให้เกิดโรคนี้สามารถส่งต่อได้ทางพันธุกรรม นั่นหมายความว่า หากเรามียีนธาลัสซีเมียในร่างกาย ทายาทของเราก็มีโอกาสเป็นผู้ป่วยธาลัสซีเมีย ทั้งชนิดรุนแรงหรือไม่รุนแรง วิธีง่าย ๆ ที่ช่วยให้รู้แต่เนิ่น ๆ ว่าทายาทของเรามีความเสี่ยงต่อโรคนี้หรือไม่ก็คือ การตรวจคัดกรองพาหะโรคธาลัสซีเมีย นั่นเอง ซึ่งเป็นการตรวจเพื่อหายีนพาหะในร่างกายของสามีและภรรยา อันจะนำไปสู่การวางแผนการมีบุตรที่เหมาะสม
แม้ว่าการตรวจคัดกรองพาหะโรคธาลัสซีเมียจะเป็นสิทธิประโยชน์ที่ทุกคนสามารถเข้าถึงได้ ก็ยังมีอุปสรรคในด้านการให้บริการและการเข้าถึงบริการอยู่ สามารถศึกษาเพิ่มเติมได้ที่นี่ครับ https://www.hitap.net/research/173411
3. เชื้อวัณโรค ทุกคนอาจเคยได้ยินชื่อของวัณโรคกันมาบ้าง โดยเฉพาะจากภาวะแทรกซ้อนของโรคเอดส์ มันคือโรคที่เกิดจากแบคทีเรียชนิดหนึ่งซึ่งแทบไม่แสดงอาการอะไรเลยในภาวะที่ร่างกายเป็นปกติ แต่เมื่อภูมิคุ้มกันในร่างกายของผู้ติดเชื้อวัณโรคลดลง อาการที่บ่งบอกถึงการมีอยู่ของวัณโรคจะเริ่มแสดงออกมา เช่น เบื่ออาหาร น้ำหนักลด รู้สึกอ่อนเพลียและเหนื่อยง่าย เป็นไข้ช่วงระยะเวลาหนึ่ง เหงื่อออกตอนกลางคืน มีอาการบวมที่คอ ใต้แขน หรือขาหนีบ เป็นต้น โดยอาการอื่น ๆ นอกเหนือจากนี้จะขึ้นอยู่กับอวัยวะที่วัณโรคเข้าถึง จึงอาจมองได้ว่าถ้าหากดูแลตัวเองให้ดีแล้วก็อาจหลีกเลี่ยงวัณโรคได้
โดยทั่วไปแล้ว วัณโรคเป็นโรคที่รักษาได้ แต่ก็เป็นโรคที่ส่งผลกระทบต่อประเทศไทยในหลายด้านมาก ถึงขั้นที่เมื่อปี พ.ศ. 2558 องค์การอนามัยโลกเคยจัดให้ประเทศไทยเป็น 1 ใน 14 ประเทศที่มีภาระวัณโรคสูงทั้งสามด้าน ได้แก่ อุบัติการณ์วัณโรค วัณโรคดื้อยาหลายขนาน และวัณโรคร่วมกับการติดเชื้อเอชไอวี หากคุณอยากรู้ข้อมูลมากขึ้น สามารถศึกษาเพิ่มเติมได้ที่นี่ครับ https://www.hitap.net/research/170457